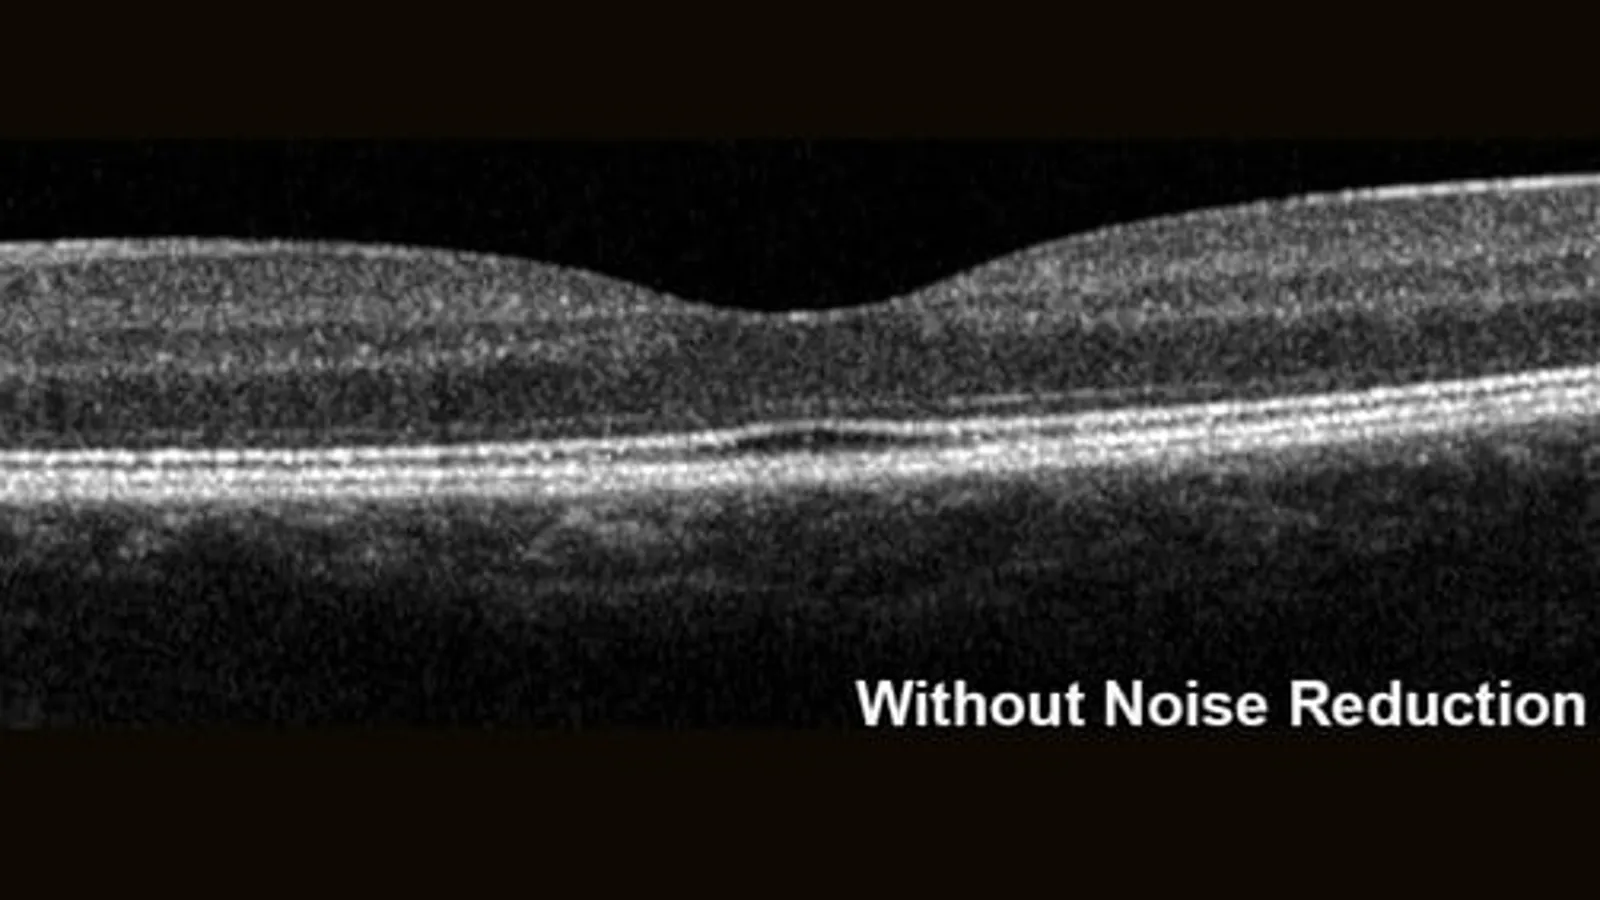
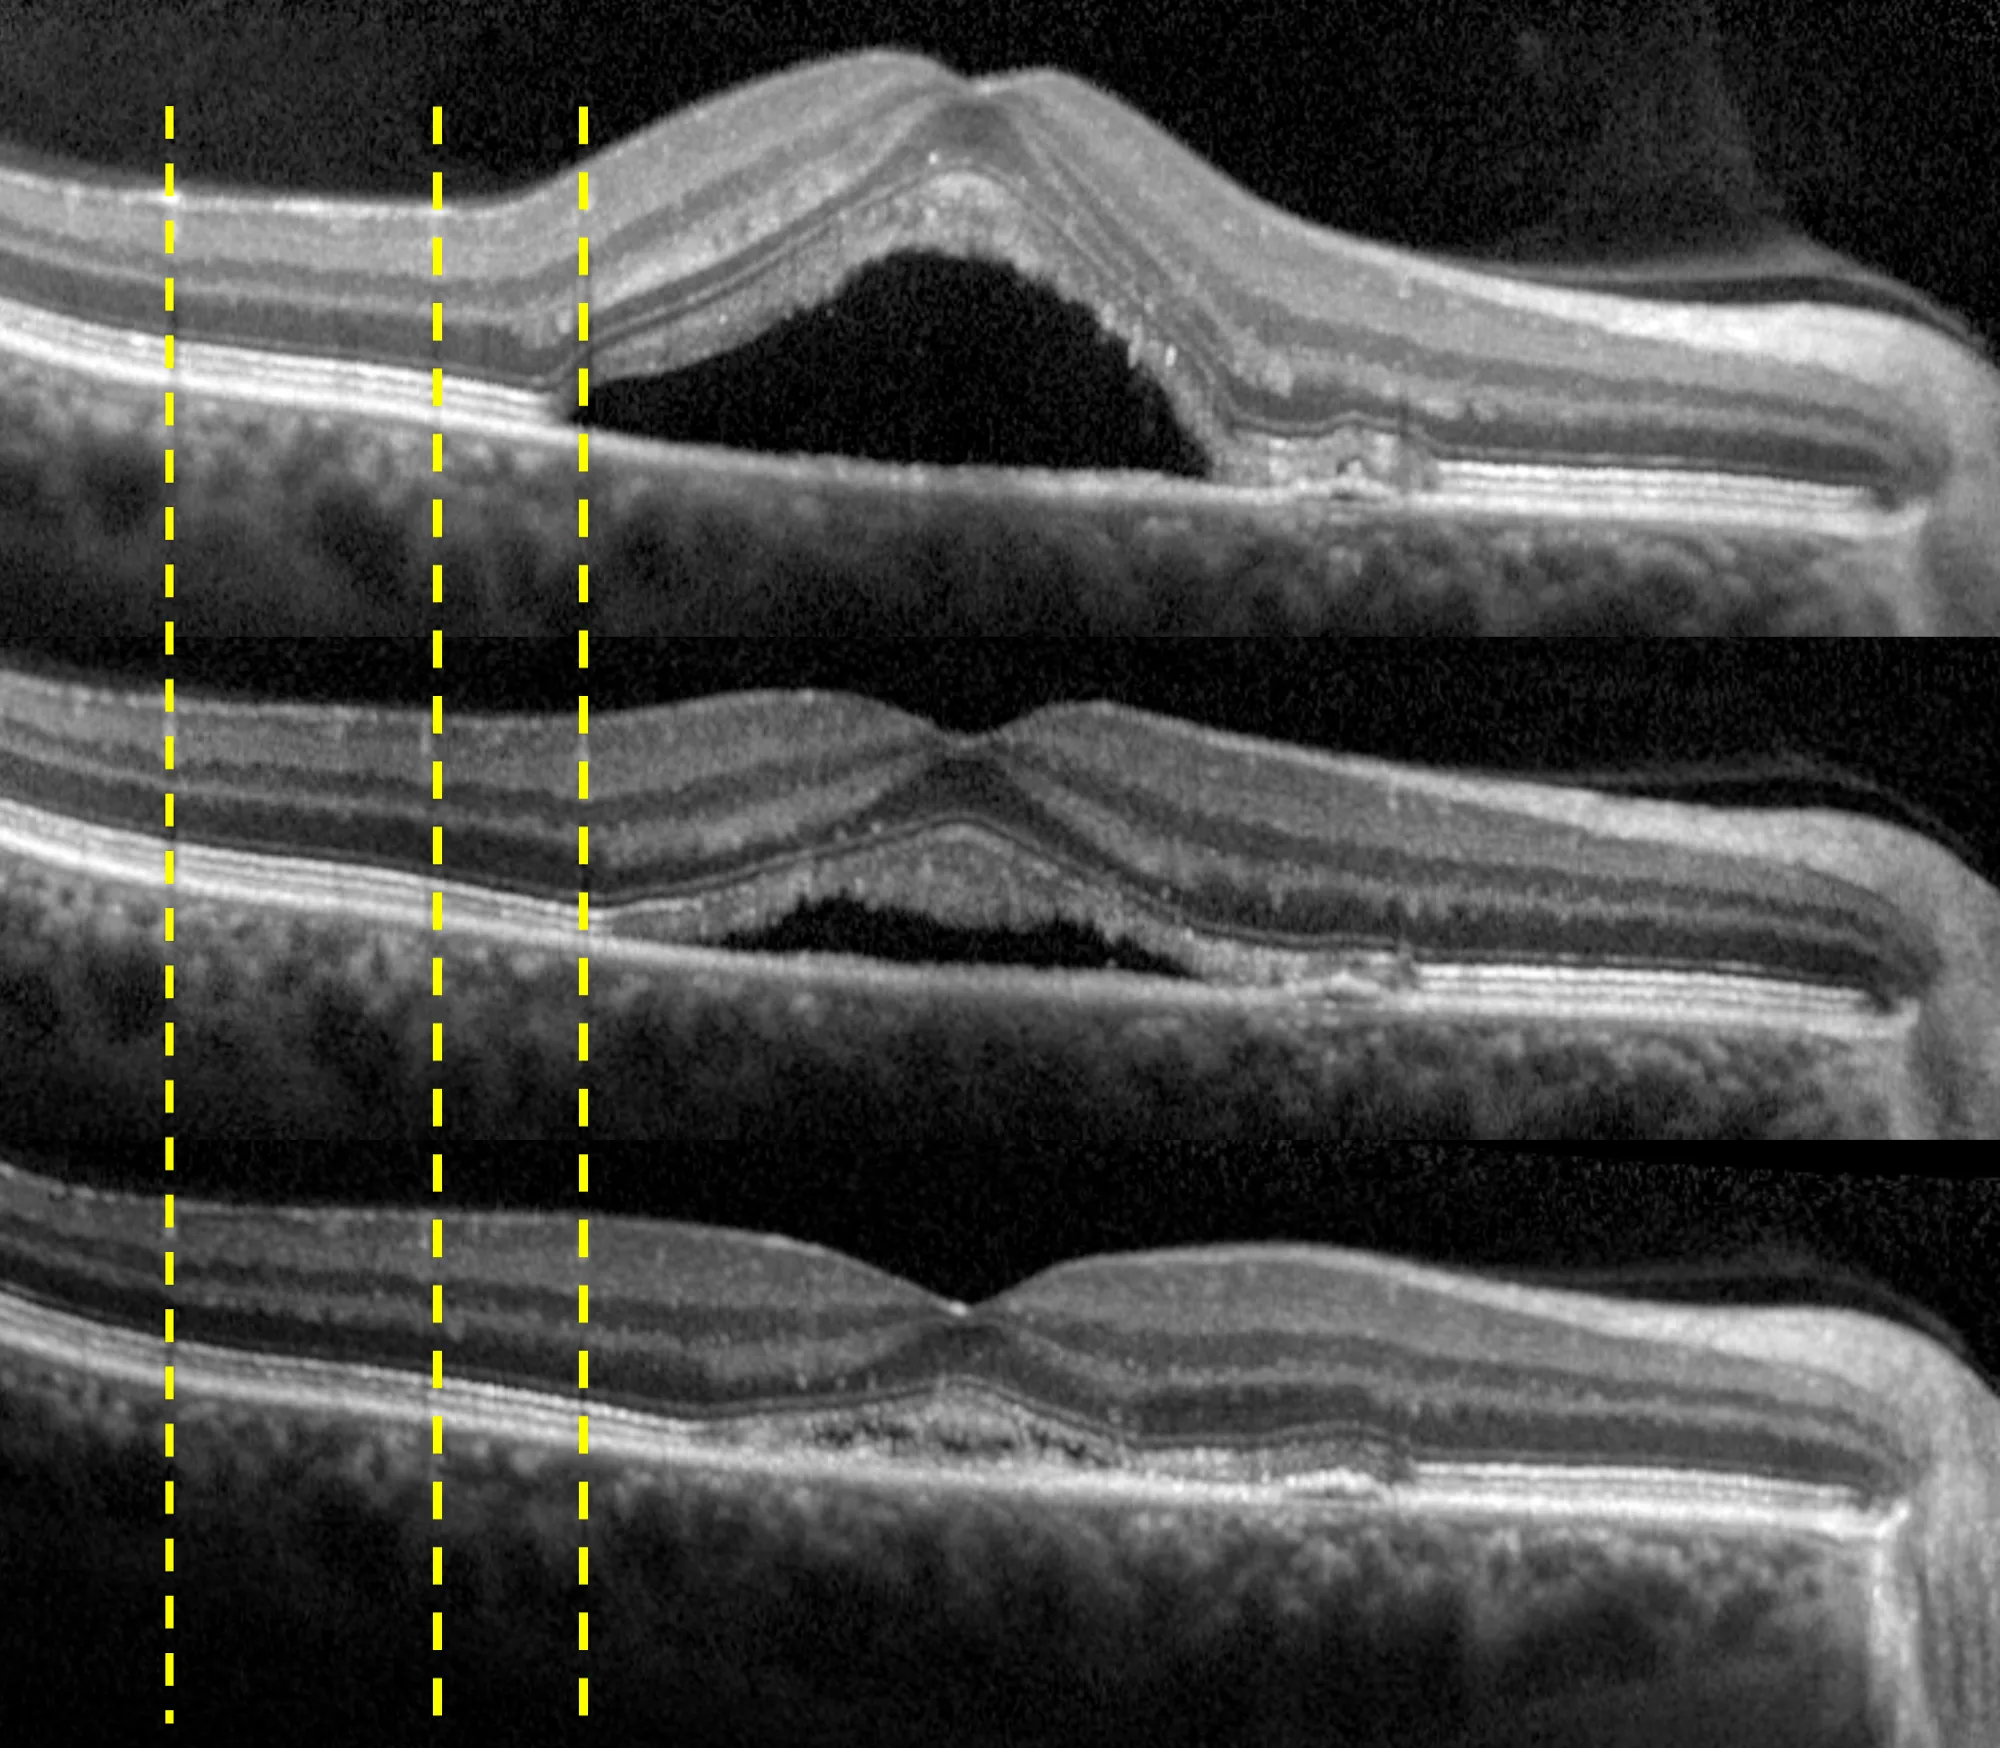

Spectralis®
SPECTRALIS® è la piattaforma di imaging multimodale che combina oftalmoscopia laser a scansione confocale (cSLO) e OCT a Spectral Domain. Il risultato è una qualità d’immagine superiore e un’elevata riproducibilità — fondamentali per decisioni cliniche affidabili e per un follow-up strutturato nel tempo.
“Comprensione completa. Fiducia diagnostica. Monitoraggio nel tempo.”
Ogni sistema SPECTRALIS integra tecnologie progettate per offrire immagini precise, flussi di lavoro flessibili e possibilità di aggiornamento nel tempo. La combinazione di hardware avanzato e algoritmi proprietari di elaborazione in tempo reale consente una visualizzazione chiara delle patologie e supporta un percorso di cura personalizzato.
Le Tecnologie Fondamentali di SPECTRALIS®
Confocal Scanning Laser Ophthalmoscopy (cSLO)

Il sistema cSLO di SPECTRALIS® offre un livello di dettaglio e nitidezza non raggiungibile con la fotografia del fundus tradizionale, grazie alla combinazione tra la selettività della luce laser e la risoluzione puntiforme della scansione confocale.
Spesso questa tecnologia rivela dettagli diagnostici fondamentali non visibili con l’oftalmoscopia convenzionale. La riduzione della dispersione luminosa permette un’imaging efficace anche in pazienti con opacità dei mezzi diottrici o pupille piccole.
TruTrack Active Eye Tracking

Il sistema brevettato TruTrack utilizza un secondo raggio laser per tracciare attivamente il fundus durante la scansione OCT in tempo reale. Questo riduce gli effetti dei movimenti oculari e consente l’acquisizione delle immagini anche durante l’ammiccamento.
Principali vantaggi clinici di TruTrack:
- Ripetibilità della misurazione dello spessore retinico fino a 1 micron
- Qualità dell’immagine eccellente su tutto il volume di scansione
- Gestione efficace dei pazienti tradizionalmente difficili da acquisire
Riduzione del Rumore (Noise Reduction)

La tecnologia proprietaria Noise Reduction acquisisce più immagini nella medesima posizione anatomica, eliminando il rumore intrinseco dell’imaging OCT e della scansione laser. Mediando in tempo reale fino a 100 B-scan, distingue le informazioni strutturali dal rumore e fornisce immagini ad alto contrasto con dettagli eccezionali, anche nelle scansioni volumetriche.
Tecnologia SHIFT

SHIFT è una tecnologia esclusiva che consente di modificare la velocità di scansione OCT per trovare il miglior equilibrio tra qualità dell’immagine e flusso di lavoro clinico — senza mai compromettere la qualità diagnostica.
Velocità di scansione disponibili:
- 20 kHz — Massimo dettaglio in occhi difficili da visualizzare (es. cataratte dense)
- 85 kHz — Equilibrio ottimale tra velocità e qualità (GMPE, diagnostica OCTA standard)
- 125 kHz — Scansioni rapide per contesti ad alto volume o pazienti poco collaborativi
Autorescan
Utilizzando l’immagine del fundus di SPECTRALIS® come mappa di riferimento, AutoRescan posiziona automaticamente le scansioni di follow-up esattamente nella stessa sede anatomica, visita dopo visita.
Un posizionamento accurato e obiettivo è fondamentale per riconoscere anche le più piccole variazioni strutturali — elementi cruciali per la gestione efficace di molte patologie oculari. Studi clinici dimostrano che SPECTRALIS, grazie ad AutoRescan, rileva variazioni dello spessore retinico fino a 1 micron.
Imaging Multimodale

La combinazione unica delle modalità di imaging di SPECTRALIS® fornisce le informazioni aggiuntive necessarie per prendere decisioni cliniche con maggiore sicurezza. È possibile configurare un sistema di imaging multimodale in base alle proprie esigenze e acquisire diverse tecniche in modo simultaneo, migliorando la comprensione di un’ampia varietà di patologie senza dover spostare i pazienti tra dispositivi e sale d’esame.
Perché scegliere SPECTRALIS®

SPECTRALIS® è una piattaforma di imaging flessibile e aggiornabile. È possibile personalizzarla in base alle proprie esigenze, con la certezza che il sistema crescerà insieme all’attività clinica.
Quando diventano disponibili nuove tecnologie, è sufficiente aggiungere nuove modalità al proprio SPECTRALIS — senza investire in nuovi dispositivi, preservando i dati dei pazienti per un follow-up preciso e garantendo un investimento duraturo nel tempo.
Scopri i Moduli della Piattaforma SPECTRALIS®
Ogni modulo SPECTRALIS aiuta a migliorare la comprensione della retina, dal vitreo alla coroide. Ogni modulo è progettato per integrarsi perfettamente nel flusso di lavoro clinico esistente.
Modulo BluePeak — Autofluorescenza Laser Blu

BluePeak è una modalità di imaging del fundus laser a scansione non invasiva che rivela malfunzionamenti metabolici di rilevanza diagnostica in condizioni come la degenerazione maculare legata all’età (AMD).
L’autofluorescenza BluePeak utilizza la lipofuscina come indicatore dello stress metabolico retinico. Combinando la segmentazione OCT con la mappatura metabolica, si rendono visibili le alterazioni morfologiche associate ai cambiamenti funzionali. Con il software RegionFinder, le aree patologiche possono essere quantificate e monitorate nel tempo.
Modulo MultiColor — Imaging Multispettrale del Fundus

MultiColor utilizza tre lunghezze d’onda laser simultanee per catturare un’immagine combinata del fundus, rivelando dettagli retinici non visibili con la fotografia convenzionale. La penetrazione variabile di ciascuna lunghezza d’onda, integrata con l’imaging OCT, fornisce dettagli strutturali che aiutano a localizzare la patologia e a identificare gli strati retinici coinvolti.
Glaucoma Module Premium Edition (GMPE)

Il Glaucoma Module Premium Edition offre un’analisi completa e personalizzata del complesso del nervo ottico e delle cellule ganglionari. Il sistema di posizionamento anatomico proprietario (APS) garantisce che le strutture fini rilevanti nella diagnostica del glaucoma vengano valutate e confrontate ad ogni visita con precisione assoluta.
Modulo di Analisi Nsite — Neurologia Retinica

Il Modulo Nsite è progettato per monitorare i cambiamenti retinici nei pazienti con neuropatie ottiche e processi neurodegenerativi, tra cui sclerosi multipla, morbo di Parkinson, ipertensione intracranica idiopatica e morbo di Alzheimer.
La retina come finestra sul cervello: il Modulo Nsite misura la proiezione neuronale e assonale all’interno della retina, offrendo una prospettiva unica sulla neurodegenerazione.
Angiografia OCT (OCTA)

Il modulo OCTA fornisce immagini ad alta risoluzione del flusso vascolare retinico in modalità non invasiva, con versatilità nel campo visivo, nella velocità di scansione (supportata dalla tecnologia SHIFT) e nella risoluzione dell’immagine.
Combinato con il sistema TruTrack, il modulo OCTA consente la segmentazione di tutti e quattro i plessi vascolari retinici convalidati istologicamente. Lo strumento PAR (Projection Artefact Removal) rimuove automaticamente gli artefatti, migliorando ulteriormente la qualità dell’immagine.
Modulo del Segmento Anteriore

Il Modulo del Segmento Anteriore consente immagini OCT ad alta risoluzione non invasive della cornea, degli angoli della camera anteriore, della sclera e delle strutture circostanti. Ideale per la valutazione dello spessore corneale e dell’angolo della camera anteriore.
Modulo di Imaging a Campo Ampio (Widefield)

Il Widefield Imaging Module offre un campo visivo di 55° per tutte le modalità di imaging del fundus — MultiColor, BluePeak, riflettanza a infrarossi, angiografia e OCT. Catturare macula, testa del nervo ottico e aree periferiche in un’unica immagine semplifica i protocolli diagnostici e facilita il rilevamento delle patologie periferiche.
Modulo di Imaging Ultra-Widefield

Il modulo SPECTRALIS Ultra-Widefield cattura un campo visivo estremamente ampio (102°) in un’unica acquisizione, con immagini uniformemente illuminate ad alto contrasto anche ai margini. Compatibile con angiografia laser a scansione con fluoresceina e ICG, acquisibili singolarmente o in simultanea.
Modulo ad Alto Ingrandimento

Il Modulo ad Alto Ingrandimento consente l’imaging cSLO ad alta risoluzione di microstrutture retiniche precedentemente impercettibili. La lente d’ingrandimento innovativa e il software dedicato dimostrano la capacità del cSLO di risolvere microstrutture oculari riducendo la diffusione della luce intraoculare — rivelando dettagli diagnostici critici non visibili con la fundoscopia tradizionale.
Angiografia a Scansione Laser (FA e ICGA)

L’angiografia laser a scansione è disponibile con fluoresceina (FA) e con colorante verde indocianina (ICG). Entrambe le modalità producono immagini ad alta risoluzione e sequenze video dettagliate del flusso vascolare. Per efficienza clinica e precisione diagnostica, FA e ICGA possono essere acquisiti simultaneamente e in combinazione con l’imaging OCT.
Il nostro team a tua disposizione
Per informazioni sui prodotti, richieste di assistenza tecnica o dettagli sui corsi di formazione, contatta Vedi Vision.

